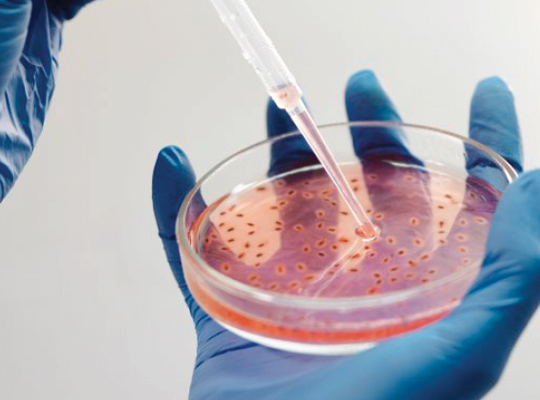

Our Service
Stem cell treatment at skinvita heals and rejuvenates skin and hair at the very level of cells. Using the ethical and clinically tested stem cell technology, this treatment stimulates collagen production, cell renewal, and natural healing. To put it simply, this therapy aims to reduce the signs of aging, improve skin texture, and promote hair regeneration. Our professionals tailor the treatments based on your unique set of concerns, covering all bases to ensure an optimal outcome. With minimal downtime and long-lasting effects, this option of stem cell treatment promises a groundbreaking approach to achieving a youthful glow and vibrant skin, as well as healthy and thicker hair naturally.
Make An AppointmentDiscover expert tips, treatment insights, and real client transformations on our YouTube channel. Stay informed, inspired, and confident about your skin and hair journey with engaging, educational, and visually stunning videos.
Visit Channel
skinvita offers a unique mixture of science and beauty in stem cell therapy. It's an applied technique that penetrates deep into the skin layer and the dormant hair follicle to cause visible rejuvenation from within. For those who seek natural yet powerful anti-aging remedies, the treatment boosts firmness, reduces fine lines, and induces the power of life. Each treatment is designed for maximum performance to give you radiant skin for a long time and restored hair confidence.